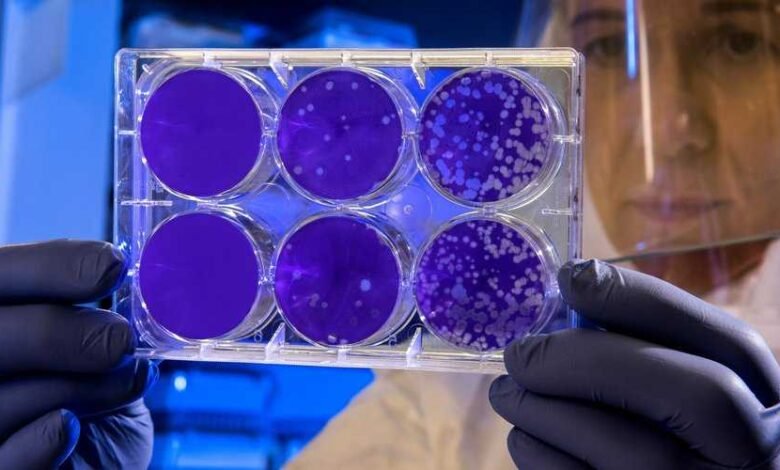

5 choses à savoir sur le Kraken, nouveau sous-variant extrêmement transmissible
Un nouveau sous-variant de la COVID, plus transmissible que jamais, le Kraken, semble être bien installé au Québec, et est désormais responsable de 45% des contaminations.
Aux États-Unis, 80% des cas de COVID sont causés par le Kraken, ou le XBB.1.5.
Ce sous-variant de la grande famille d’Omicron n’est pas plus dangereux ou plus grave, mais beaucoup plus transmissible.
Il a été décrit comme la souche la plus transmissible à ce jour, plus contagieux que ses prédécesseurs.
«Même les personnes qui ont une protection par la vaccination ou qui ont eu la COVID-19 récemment ont été infectées», a expliqué le spécialiste des maladies infectieuses le Dr Scott Roberts, à la revue Yale Medicine.
1- D’où vient XBB.1.5 ?
XBB.1.5 a été identifié pour la première fois aux États-Unis à New York en octobre 2022. XBB et le Kraken (XBB.1.5) sont des sous-variants virales recombinantes (ou hybrides), ce qui signifie qu’ils sont composées de deux souches – dans ce cas, deux ramifications de la sous-lignée Omicron BA.2, rapporte la revue Yale.
On pense que les deux souches ont infecté une personne et se sont mélangées pour former l’hybride XBB, qui a engendré des mutations supplémentaires. «Les virus de la grippe font cela tout le temps», explique le Dr Scott Roberts. «C’est une autre façon dont le virus peut muter et c’est quelque chose à surveiller.»
2- Pourquoi le «Kraken» ?
Le Kraken est un monstre marin géant mythique à plusieurs tentacules, comme un calmar géant ou une pieuvre, dans la tradition scandinave. XBB.1.5 a été surnommé «Kraken» par certains scientifiques qui ont remarqué sa propagation rapide.
3- Dans quelle mesure XBB.1.5 est-il transmissible ?
L’Organisation mondiale de la santé (OMS) a qualifié XBB.1.5 de souche d’Omicron la plus transmissible à ce jour. Aux États-Unis, il s’est propagé comme une traînée de poudre dans la région de la Nouvelle-Angleterre, où les infections ont augmenté sur une courte période pour atteindre près de 94% des cas, comme l’ont signalé les Centers for Disease Control and Prevention (CDC) début février.
4- Dans quelle mesure les vaccins fonctionnent-ils contre XBB.1.5 ?
Il faudra du temps pour rassembler les données à long terme pour montrer à quel point les vaccins fonctionnent contre XBB.1.5. Le Dr Roberts dit que ceux qui ont reçu le rappel bivalent Pfizer-BioNTech ou Moderna sont susceptibles d’avoir une protection décente, en particulier contre les maladies graves et la mort.
5- Les gens devraient-ils s’inquiéter d’une nouvelle vague de cas de COVID-19 ?
«Même avec une augmentation des cas, les chiffres ont été inférieurs à ceux des vagues précédentes, et à ce stade, le virus a muté pour devenir plus doux», explique le Dr Scott Roberts. «J’espère que cela pourra atteindre un stade où l’infection ne devrait pas avoir un impact majeur sur nos vies.»
Toutefois, il est important de savoir que les personnes à haut risque de maladies graves seront toujours plus susceptibles d’être infectées.
De plus la COVID longue demeure un mystère pour la science et peut rendre la vie de personnes en bonne santé très difficile en raison de ses complications.



